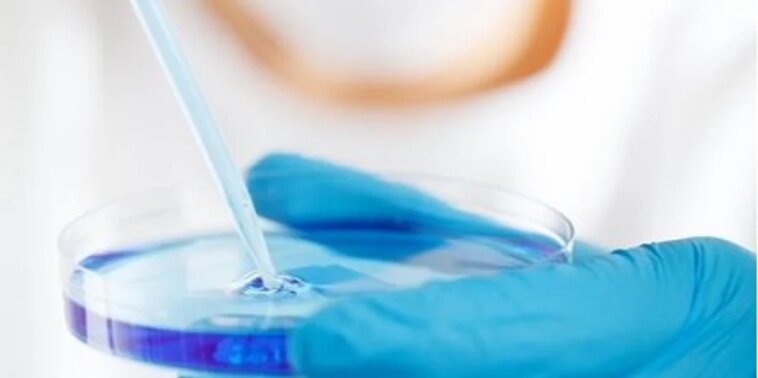

Міжнародна команда дослідників під керівництвом Кельнського університету оголосила про відкриття антитіла, здатного нейтралізувати майже всі відомі варіанти ВІЛ.
Прорив у профілактиці та лікуванні. Вчені відкрили антитіло, що блокує майже всі штами ВІЛ